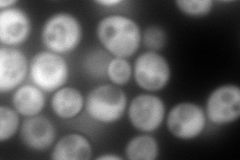
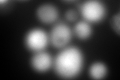

View description
Cytoplasmic inorganic pyrophosphatase (PPase), homodimer that catalyzes the rapid exchange of oxygens from Pi with water, highly expressed and essential for viability, active-site residues show identity to those from E. coli PPase
Localization:
Intensity:
Fold change:
Significance:
-
C’ GFP library in SD

cytosol381.03 -
N' NOP1pr-GFP in SD
cytosol517.11 -
N' TEF2pr-mCherry in SD

cytosol770.088 -
N' NATIVEpr-GFP in SD

missing0 -
N' TEF2pr-VC and Cyto-VN in SD

cytosol97.4596 -
C’ GFP library in SD+DTT
cytosol502.31.31No -
C’ GFP library in SD+H2O2

cytosol345.770.9No -
C’ GFP library in Starvation Media

nucleusN/AN/AYes -
C’ GFP library on the background of Pup2-DaMP

cytosol -
C’ GFP library on the background of CCT mutant

cytosol283.880.745025No
